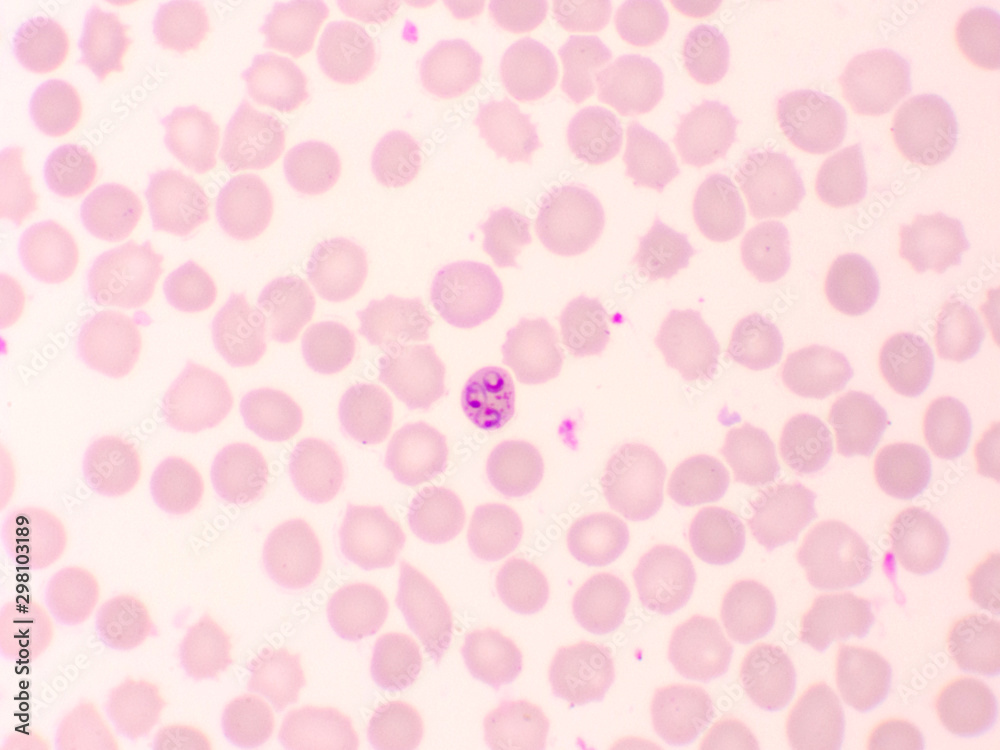

Malaria parasite in red blood cells, ring form stage of Plasmodium falciparum, original magnification 1000x
Customised Wallpaper Mural
From $100.00 Original price was: $100.00.$80.00Current price is: $80.00.

DIGITALDECOR Shopping Event
Get Upto 30% OFF on your first order! Apply Coupon Code "DIGITALDECOR" at checkout
Made to Measure
Sustainable
Free Customizations
Free Worldwide Shipping
Our categories
Lots of new products and product collections
Customised Wallpaper Mural
From $100.00 Original price was: $100.00.$80.00Current price is: $80.00.
Feather Texture
Finish : Textured
Adhesive Required
Non Woven
Finish : Smooth
Adhesive : Required
Lined Texture
Finish : Textured
Peel & Stick
Self Adhesive Vinyl
Finish : Matte
Peel & Stick
Canvas Gloss
Finish : Glossy
Adhesive Required
Canvas Matte
Finish : Matte
Adhesive Required
Authorities in our business will tell in no uncertain terms that Lorem Ipsum is that huge, huge no no to forswear forever. Not so fast, I'd say, there are some redeeming factors in favor of greeking text, as its use is merely the symptom of a worse problem to take into consideration.
Anyway, you still use Lorem Ipsum and rightly so, as it will always have a place in the web workers toolbox, as things happen, not always the way you like it, not always in the preferred order.
Customised Wallpaper Mural
Elevate your home decor with custom wallpaper from Toronto Digital Wall Coverings. Our printed wall coverings allow you to transform any room into a unique and personalized space. Whether you want to showcase your favorite memories or create a stunning focal point, our custom wallpaper is the perfect choice.
Our custom wallpaper murals are the perfect solution! Made to measure and printed with high-quality HP latex inks, our murals are available in a variety of materials, including matte vinyl, canvas, peel and stick, feather texture, lined texture, and traditional paper. Whether you want a dramatic statement piece or a subtle touch of personalization, we have a custom wallpaper option to suit your style.
Our team of experienced designers can help you create a truly unique and beautiful mural that reflects your personal style. Choose from a vast library of images or upload your own design for a truly personalized touch. We also offer a wide range of sizes and finishes to ensure your custom wallpaper mural seamlessly integrates with your space.
Material Options
Non Woven
Finish : Smooth
Adhesive : Required
Feather Texture
Finish : Textured
Adhesive Required
Lined Texture
Finish : TexturedPeel & Stick
Matte Self Adhesive
Finish : Matte
Peel & Stick
Canvas Texture
Finish : Canvas
Adhesive Required
Canvas Self Adhesive
Finish : CanvasPeel & Stick
| Material | , , , , , |
|---|
Frequently Asked Questions
How long will my wallpaper mural stay up?
Life of your custom printed mural wallpaper depends on the surface the mural is applied to. A mural will last for many years in the environment it’s installed. Proper Surface Preparation & Cleaning the wall before installation is key to making a Wallpaper mural last for years to come.
Can I use my wallpaper mural outdoors?
Our custom printed walls murals can be installed outside on a short-medium term. It is not recommended for any longer than a few months due to the harsh weather conditions that can affect the adhesive and inks.
Which shipping provider is used to ship my wallpaper?
We ship all our orders using Canada Post and DHL.
How long will it take between the time I order Walls Mural and the time I receive it?
It usually takes from 2 to 5 business days to process and print your order and, depending upon your preferred shipping method, another 1 to 6 business days to reach you.
Are custom printed wallpapers safe?
- HP Latex Inks: HP Latex inks are water-based and non-toxic. Unlike solvent-based inks, they release minimal VOCs (volatile organic compounds), which are harmful chemicals.
- GREENGUARD Certification: This certification guarantees we meet strict standards for low chemical emissions, ensuring a healthier indoor environment for you and your family.
- Eco-Friendly Materials:We offer various wallpaper materials that are non-VOC and environmentally responsible. This means your wallpaper won’t contribute to harmful off-gassing.
Do you have any commercial grade wall murals?
Yes, our Canvas Texture material is Type 2 wall covering material, can be used in all sorts of commercial & retail spaces.
Does my wall need a primer before installing wall coverings?
Priming promotes adhesion, seals the wall and protects it against moisture. It can also prevent the wall covering adhesive from soaking into the wall, thus making it easier to remove the wall covering later.
All walls (drywall, plaster) should be primed with a quality, adhesion promoting, acrylic or latex wall covering primer. If a moist wall condition exists, an oil-based primer may be used to create a waterproof barrier. If an oil-based primer is used, always apply an acrylic or latex primer over it before hanging the vinyl wall covering.
What can I do if the shipment is damaged?
Please check the product for damage immediately upon delivery. Your product will be replaced free of cost . Please contact via email info@torontodigital.ca/shop for assistance.
Delivery Info
We’re committed to bringing exceptional design to your doorstep, anywhere in the world. Enjoy free, fast shipping on all orders over $500.
Delivery Timeline
Your custom design will be printed, dispatched, and delivered within 5-10 working days after payment confirmation.
For more details, visit our delivery information page.
Wallpaper Design Customisation
At Toronto Digital Wallpapers, we believe in giving you the freedom to customize your wallpaper to your heart's content. Our free customization service allows you to tailor any design to your exact specifications.
Common Customization Options:
Subject Adjustments: Move, add, or remove elements within the design.
Color Customization: Change colors to suit your taste or match your room's palette.
Personalization: Incorporate names, logos, or personal messages.
Pattern Resizing: Scale patterns to fit your space or aesthetic.
How to Customize:
Once you've placed your order, email us your customization request. Include any design details or changes you'd like to make.
Turnaround Time:
We'll review your request within 1-2 working days. If your request is clear, our designers will work on it and provide a preview. If we need more information, we'll contact you to discuss further.
Customer Reviews
119 reviews for Customised Wallpaper Mural
Clear filtersYou must be logged in to post a review.
Customer Photos














Top Rated Wallpapers
Pink Peony Paradise Wallpaper – Floral Peel and Stick Wall Mural – Romantic Bedroom Decor & Living Room – Wallpaper for Girly Spaces
Urban Subway Tunnel Wallpaper – Industrial Wall Mural – Modern Home Office & Entryway – Black & White Wallpaper
Golden Mountain Escape Wallpaper – Modern Landscape Wall Mural – Yellow & Gray Bedroom Decor – Peel & Stick Wallpaper
Vibrant Autumn Leaves Wallpaper – 3D Forest Wall Mural – Orange & Yellow Wallpaper for Cozy Maximalist & Nature Spaces
Blue & Gold Grunge Wall Mural – Distressed Urban Wallpaper – Bold Home Office & Entryway – Textured Wallpaper
Moroccan Archway Wall Mural – 3D Islamic Architecture Wallpaper – Black & White Entryway & Living Room Decor – Modern & Luxury Home Mural
Learn About Your Custom Wallpaper
Transform your walls with bespoke wallpaper handmade to order, offering a unique and customizable wall-covering solution. With a 10-year guarantee and available in any size to fit your space, you have full control over the design process.
Key Features at a Glance:
- Customizable designs: Photo or Repeat Pattern Wallpaper
- Eco-friendly materials: Matte finish with water-based inks
- Easy installation: Peel & stick or adhesive-backed options
- Custom sizes available.
Design Tips
- Choose Your Style: Decide between Photo/Montage Wallpaper (a single image across the wall) or Repeat Pattern Wallpaper (a tiled design).
- Measure Accurately: Add 2-4 inches for trimming.
- Upload Your Design: Use our online design system to upload your image perfectly.
Applications
For Homes: Personalize your living spaces with unique designs, such as family photos or custom illustrations—perfect for feature walls or entire rooms like nurseries or bedrooms.
For Businesses: Showcase your brand's identity by creating custom wallpapers tailored to your restaurant, café, or office ambiance—whether romantic, fun, or professional.
For Designers: Elevate your art portfolio by turning your creations into bespoke wallpapers that appeal to interior design enthusiasts and clients alike.
Installation Made Easy
Full hanging instructions are provided with every order, ensuring a smooth installation process regardless of the paper type you choose.
Start designing your bespoke wallpaper today at Toronto Digital!































David B. (verified owner) –
Great customer service and great product!
EchoEssence (verified owner) –
Easy odd shape fitting
Taylor Canne (verified owner) –
Very Vibrant Printing. Kids love it. Easy to Clean.
Karen D. (verified owner) –
Highly recommend!